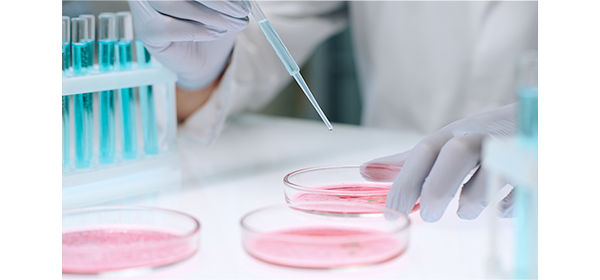

関節・神経・内臓。あなたの症状に合わせた幹細胞治療を。
東京・大阪・札幌の3院で、厚生労働省届出済の再生医療をご提供。
※1 2019年6月〜2026年1月末時点の東京院・大阪院・札幌院3院で取り扱う全治療数の累計

リペアセルクリニックでは、関節・神経・内臓・美容の幅広い分野で再生医療を提供しています。あなたの症状に合わせた治療をご提案します。

変形性ひざ関節症、股関節症、半月板損傷、肩腱板損傷

脳卒中、椎間板ヘルニア、脊柱管狭窄症、脊髄損傷

糖尿病、肝臓疾患

肌再生、免疫細胞療法
相談だけでもOK。治療を強制することはありません。
リペアセルクリニックは、厚生労働省に届出・受理された再生医療専門クリニックです。

厚生労働省に届出・受理された「分化誘導による関節の再生医療」を提供。再生医療安全確保法のもと、安全な治療体制を整えています。

理事長 坂本貞範をはじめ、各院に再生医療に精通した専門医が在籍しています。

理事長の著書はAmazonランキング複数部門で1位を獲得(2020年発売時点、医学・薬学カテゴリ)。テレビ等メディアでも多数紹介されています。

冷凍保存せず、投与直前に培養した新鮮な幹細胞を使用。細胞生存率96%。高い治療効果が期待できます。

必要なところに必要なものを届ける技術。幹細胞を目的の組織に変化させる分化誘導により、軟骨の再生を促します。

幹細胞の投与数が多いほど高い効果が期待できます。培養技術により最大2億個まで増やして点滴投与いたします。
独自開発の分離シートで、強い細胞をつくります。化学薬品を使わず、幹細胞にダメージを与えることなく安全に抽出します。

培養にはご自身の血液を使用。代用血液(牛血清・人工血清)や脂肪分解酵素(化学薬品)は一切使いません。

関節内ピンポイント注射、脊髄腔内ダイレクト注射療法など、熟練の医師による独自の投与技術で高い治療効果を目指します。
初回カウンセリングで、医師が丁寧にご説明いたします。
リペアセルクリニックで幹細胞治療を受けられた方の症例をご紹介します。
※治療効果には個人差があります。すべての方に同様の効果を保証するものではありません。

ヒアルロン酸注射で効果がなく、人工関節を勧められていた方。幹細胞5,000万個の投与3ヶ月後に痛みが大幅改善。

人工関節を勧められていた方。1億個を2回投与し、最終投与後1年で痛み完全消失。日常生活を取り戻されました。

関節鏡手術を勧められていた方。5,000万個を3回投与し、半年後に痛み消失。ゴルフ講師の仕事にも復帰されました。

脳出血(右視床出血)による左半身麻痺。発症2週間後に2億個を3回投与。握力が2.4倍に回復し、杖なし歩行が可能に。

頚椎症性脊髄症の術後も症状が残存。脊髄腔内に2,500万個を3回投与。歩行距離が約17倍に改善し、膀胱直腸障害も改善。

毎月の穿刺・ヒアルロン酸注射で効果がなかった方。5,000万個の投与とPRP併用により半年後に大幅改善。趣味のテニスを痛みなく楽しめるように。
※上記はすべて個人の治療経過であり、効果を保証するものではありません。治療効果には個人差があります。

お電話またはWebから、お気軽にご相談ください。ご予約は完全予約制です。

必要に応じてMRI検査を予約。現在の状態を正確に把握します。

医師が検査結果をもとに、丁寧にご説明いたします。

ご同意いただいた治療計画に基づき、幹細胞治療を開始します。
相談だけでも歓迎です。まずはお話をお聞かせください。
多くの方が同じように感じています。どうぞご安心ください。
「治療は痛いですか?仕事は休む必要がありますか?」
脂肪の採取は局所麻酔で約30分、投与も注射のみで日帰りです。翌日からお仕事に復帰される方がほとんどですので、お忙しい方もご安心ください。
「他の病院で手術しかないと言われたのですが…」
手術を勧められた方、他院で治療が難しいと言われた方も多くご相談いただいています。再生医療という新たな選択肢として、セカンドオピニオンとしてもお気軽にご活用ください。
「遠方に住んでいるのですが、通えますか?」
東京・大阪・札幌の3院で対応しております。初回のご相談はオンラインでも可能です。来院回数が最小限で済むよう、治療スケジュールを調整いたします。
「家族にまだ話していなくて…」
まずはお一人でご相談いただいて大丈夫です。ご相談内容をまとめた資料もお渡しできますので、ご家族とのご相談にお役立てください。
「自分の症状に再生医療は使えるの?」そんな疑問に、専門医が丁寧にお答えします。
あなたの症状に幹細胞治療が適用できるか、専門医が判断します。
回数・期間・期待される効果をわかりやすくご説明します。
治療にかかる費用を明確にご提示。隠れた追加費用はありません。
痛み・副作用・生活への影響など、どんな質問にもお答えします。
相談したからといって、治療を受ける必要はありません。
「まだ迷っている」「情報収集の段階」という方も、お気軽にお越しください。
再生医療があなたに合うかどうか、まずは専門医に相談してみませんか。無理な勧誘は一切いたしません。
保険適応には国の認可が必要です。審査には長期間を要し、新しい医療技術をすぐに保険で行うことができません。海外で行われている治療であっても日本でもう一度審査が必要です。
ご自身の細胞を使用するため、拒絶反応のリスクが極めて低いとされています。当院は第二種・第三種再生医療等計画を厚生労働省に提出し受理されました。再生医療安全確保法に基づき、特定再生医療認定委員会の厳しい審査を経て、安全な再生医療を提供できる体制が整っています。
治療の効果は実感できると考えます。ただし全ての治療に言えることですが、人により個人差があります。1回の治療で全て治るとは言えません。複数回行う方が高い効果を実感できます。症状や状態に合わせた最適な治療を提供します。
一人ひとりの診察に十分な時間をとり、待ち時間を少なくするために予約制となっております。電話またはメールでお問い合わせいただけます。
紹介状は必須ではありません。ただし以前治療や手術を受けたことがある方は、治療内容の確認が必要な場合があります。その際は紹介状など治療内容がわかるものをご提供ください。
保険証並びにお薬手帳をお願いいたします。紹介状やMRIのデータもございましたらお持ちください。
術前の血液検査にて感染症が発見された場合は受けられないことがあります。
医療費控除の対象になることが多いです。当クリニックで必要な領収書を発行しております。医療費控除対象になるかは管轄の税務署によって異なるため、詳細は直接管轄の税務署にお問い合わせください。
当クリニックと提携しているクレジットカードがご利用になれます。事前にご利用限度額等ご確認の上、受付時にお申し出ください。
リペアセルクリニックは、医療法人美喜有会が運営する、自己脂肪由来の幹細胞を用いた再生医療専門クリニックです。2019年の開院以来、累計14,000例以上の治療実績があり、厚生労働省に第2種・第3種再生医療等提供計画を届出しています。
最大の特長は、冷凍保存せず治療の都度新たに培養するオリジナルの「リペア幹細胞」。薬剤・化学物質を使わない独自の培養技術で細胞の生存率と活動率を高め、学会でも高い評価を受けています。在籍医師は全員が日本再生医療学会に所属する専門医です。
変形性ひざ・股関節症、頚椎・腰椎ヘルニア、脊髄損傷、脳卒中、スポーツ医療など幅広い疾患に対応。遠方の方にはオンラインカウンセリングも実施しており、ご家族とご一緒のご相談も可能です。



自己脂肪由来の幹細胞を培養し、関節内注射・脊髄腔内注射・点滴投与により患部に届ける再生医療です。厚生労働省に第二種・第三種再生医療等提供計画を届出・受理されています。自由診療(保険適用外)となります。
※治療プランは症状により異なります。費用の詳細はカウンセリング時にご説明いたします。料金一覧はこちら